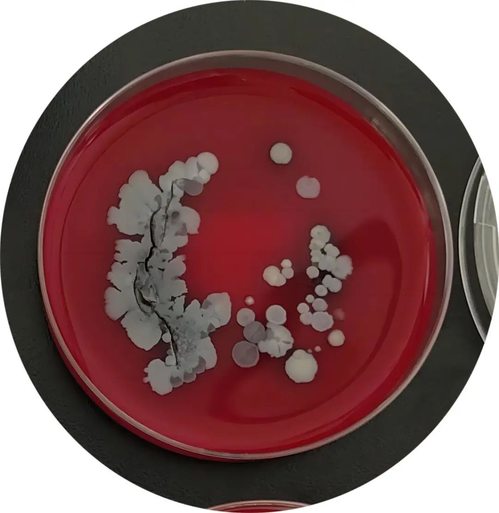
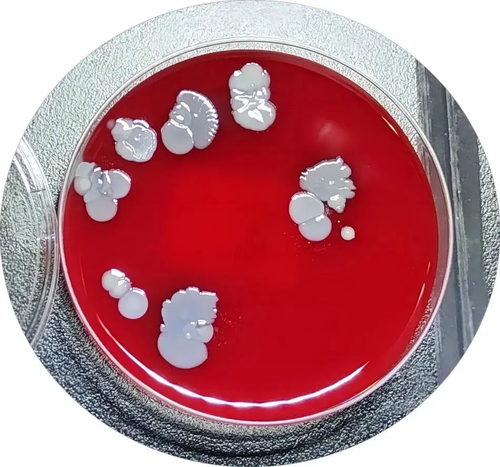
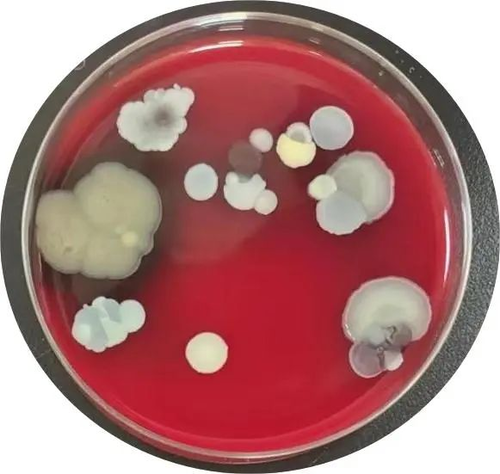
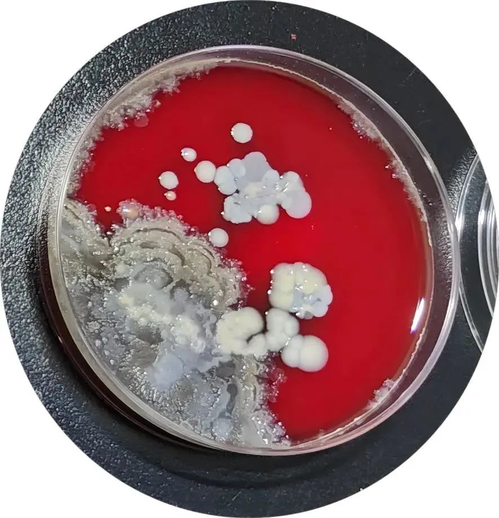
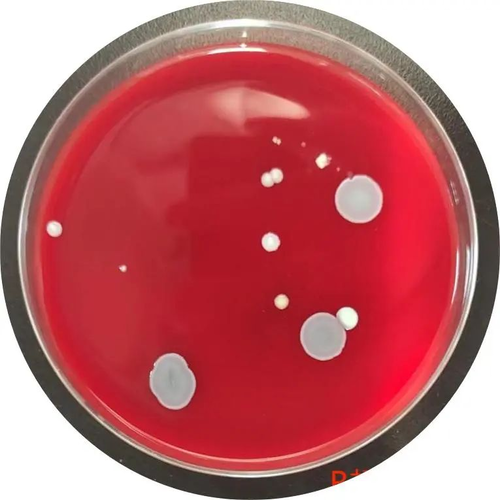
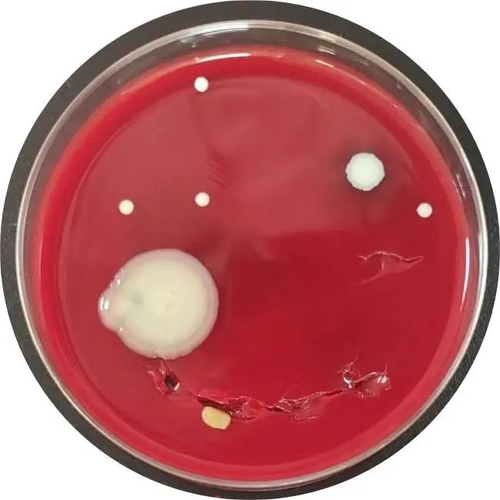

(荔枝新闻讯 通讯员/张卉)5月5日是世界手卫生日,由世界卫生组织(WHO)于2009年倡议发起,旨在强调医疗护理过程中提高医务人员手部卫生、减少医源性感染的重要性。今年迎来第15个世界手卫生日,本次的口号是:共同加快行动,拯救生命,清洁您的双手。
南京市妇幼保健院感染管理办公室采用手部直接拓印进行细菌培养的方式,模拟真实场景,采集了临床医务人员、医技人员工作中的手部样本,更加直观、可视化的展现平时肉眼不可见的细菌。
模拟日常工作中的你、我、他
如果工作后,没洗手......
产科的你:约100 CFU/皿,表皮葡萄球菌+鲁氏不动杆菌
妇科的你:35 CFU/皿,表皮葡萄球菌+鲁氏不动杆菌
新生儿科的你:30 CFU/皿,表皮葡萄球菌+革兰氏阳性杆菌
外科的你:45 CFU/皿,表皮葡萄球菌+鲍曼不动杆菌
B超室的你:13 CFU/皿,表皮葡萄球菌+纽氏副球菌
检验科的你:7 CFU/皿,表皮葡萄球菌+耳炎苏黎世菌
常见致病菌的解读
鲍曼不动杆菌
鲍曼不动杆菌是一种专性需氧、非乳糖发酵的条件致病菌,不具鞭毛,移动性不高,但生命力极强,在干燥的物体表面可存活25天。对湿热紫外线及化学消毒剂有较强抵抗力,因此常规消毒只能抑制其生长而不能杀灭。鲍曼不动杆菌广泛分布于医院环境,具有强大的获得耐药性和克隆传播的能力,易在住院患者皮肤、结膜、口腔、呼吸道、胃肠道及泌尿生殖道等部位定植,当机体免疫力下降时会发生感染,已成为我国院内感染最重要的病原菌之一。根据2021年CHINET 中国细菌耐药监测数据显示鲍曼不动杆菌位居临床检出排名前五位的细菌,且其多重耐药细菌的检出率呈快速上升趋势。
表皮葡萄球菌
表皮葡萄球菌是栖居人体皮肤上的最优势的种群之一,是人类皮肤上的主要共生菌,也是构成皮肤微生物的主要成员之一,在维持皮肤微生物平衡方面起重要作用,当皮肤微生物失调时,可作为条件致病菌引起感染,如尿路感染、与手术操作和导管相关性感染。对于新生儿这类自身的免疫系统尚未建立完善的患者存在一定的感染风险。

感控小贴士
1.医务人员使用皂液+流动水洗手或快速手消后,虽可去除大部分暂居菌,但也依然有条件致病菌的存在,所以不仅要严格遵从洗手的“5个洗手指征”,同样重要的是,保证洗手质量。
2.需要高度重视多重耐药菌感染患者的隔离、防护和手卫生。
3.当手部有血液或其他体液等肉眼可见的污染时或可能接触艰难梭菌、肠道病毒、手足口、轮状病毒等对速干手消毒剂不敏感的病原微生物时应用皂液和流动水洗手,揉搓不少于15秒。
4.外科洗手后,进行外科手消毒流程:手指尖浸泡在手消毒剂中(≥5秒),将手消毒剂涂抹在手、前臂直至上臂下 1/3,双手分别进行,而后须再次取适量的手消毒剂放置在手掌上,严格按步骤揉搓双手至手腕,直至手部干燥。
为了预防与卫生保健相关感染和微生物药物耐药发生,重视改善手部卫生,阻断细菌在医院内的传播,预防疾病在医院感染流行,需要患者、家属、医务人员共同加入行动,做好手卫生,我们倡议:让我们齐心协力,加快行动,营造安全、高质量的手卫生文化!

参考资料:
1、2021年CHINET中国细菌耐药性监测结果
2、中国鲍曼不动杆菌感染诊治与防控专家共识.
3、感染新生儿的表皮葡萄球菌临床分离株耐药及分子特征分析
4、医院感染预防与控制标准操作规程
5、医务人员手卫生规范






公安备案号:32010202010067